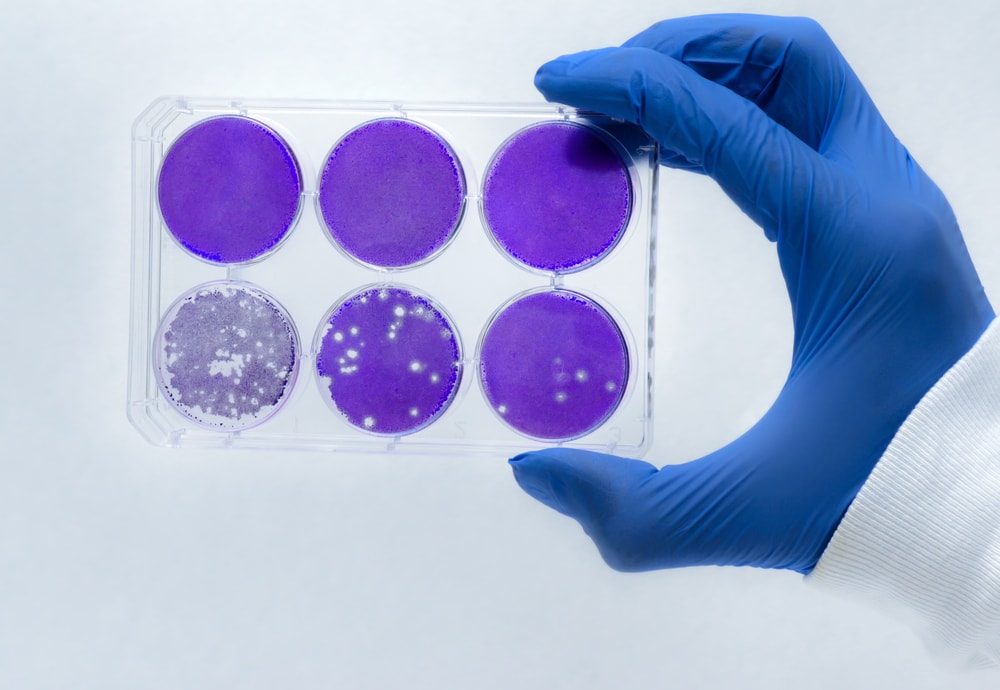
Cyfrowe DNA: możemy je tworzyć, nadpisywać. Czy to dobrze?

Wraz z połączeniem się światów biologii i informatyki powstaje nowa gałąź ludzkich działań i badań – bio-cyber-bezpieczeństwo. Brzmi skomplikowanie? Nazwa nawet w ułamku nie oddaje zawiłości zagadnień i problemów, którym będzie się zajmować. Jakie to będzie fascynujące!
Już teraz naukowcy, politycy, analitycy, inżynierowie i twórcy oprogramowania dyskutują o wielu z potencjalnych zagrożeń, a jest o czym rozmawiać.
W 2010 roku w irańskiej elektrowni jądrowej doszło do tajemniczego wypadku. Sprzęt na pewien czas zaczął zachowywać się nie tak jak powinien. Kilka miesięcy później firma zajmująca się zabezpieczeniami została wezwana do pozornie niezwiązanego z tamtymi wydarzeniami problemu. Informatycy odnaleźli wirusa o nazwie Stuxnet, którego zadaniem było wprawianie urządzań w wibracje. Skutek? Wyłączenie jednej trzeciej urządzeń w elektrowni i silny cios dla irańskiego programu energetyki jądrowej.
W przeciwieństwie do większości wirusów Stuxnet nie atakował tylko komputerów. Atakował także inne urządzenia, które komputery kontrolowały. Działał środowiskowo.
Obecnie z pomocą komputerów możemy kształtować nowe organizmy, modyfikować genom, wprowadzać automatykę w tworzeniu leków, poprawiać bezpieczeństwo produkcji żywności.
Stuxnet pokazał, że brak odpowiednich zabezpieczeń może doprowadzić do “wylania się” zagrożenia z komputerów do biologicznego świata. Natychmiast przychodzą nam do głów skrajnie różne scenariusze: terroryści używający oprogramowania do wypuszczania chorób z laboratoriów z jednej strony, a z drugiej leki, które mogłyby ratować życie natychmiast, prosto z komputerów.
Łatwość, z jaką można obecnie badać i testować możliwości genetyki sprawiła, że takie badania przestały być domeną największych i najbogatszych sił i firm. Małe laboratoria, pojedynczy naukowcy mogą eksperymentować na cyfrowym DNA. Granica między tym, co cyfrowe, a biologiczne powoli zaczyna się zacierać. Zapisane w DNA złośliwe oprogramowanie? Jak najbardziej, to już nie science fiction. Instytut J. Craig Venter chwali się opracowaniem syntetycznego genomu z zapisanymi odnośnikami i ukrytymi komunikatami.
20 lat temu inżynieria genetyczna pozwalała nam na tworzenie nowych łańcuchów DNA poprzez łączenie innych, naturalnie powstałych molekuł. Dziś możemy używać zaawansowanej biochemii by wytwarzać sztuczne łańcuchy w całości. Jeśli potrzebujemy do badań fizycznej próbki czegoś – możemy ją wytworzyć laboratoryjnie. Oczywiście stwierdzenie, że każdy kto ma dostęp do internetu może stworzyć niebezpiecznego wirusa jest przesadzone – ale tylko trochę. Amerykańskie Centrum Kontroli i Przeciwdziałania Chorobom użyło w 2005 roku opublikowanego w internecie opisu DNA do zrekonstruowania wirusa grypy hiszpanki. Rok później pewien dziennikarz skorzystał z publicznie dostępnych danych by zamówić próbkę DNA ospy. Otrzymał ją… pocztą.
Do tej pory rozmowy o bio-cyber-bezpieczeństwie skupiały się na wielkich katastrofach. Są dwa rodzaje scenariuszy: w pierwszym z nich wirusy, takie jak Stuxnet, mogą włamywać się do laboratoriów i maszynerii kontrolowanych przez komputery i powodować ich niepożądane działanie. Inny zakłada ludzi, którzy wykorzystają programy i bazy danych do rekonstruowania pokonanych niegdyś chorób lub wymarłych patogenów.
Nie chodzi tu tylko o “czarne charaktery” w rodzaju terrorystów, samotnych wilków czy szalonych polityków. Zagrożeniem może być zwyczajny ludzki błąd, nieintencjonalny. Taki błąd co prawda nie wypuści na świat groźnego wirusa, ale może na przykład zniszczyć gigantyczne partie jakiegoś produktu, zagrozić bezpieczeństwu narodowemu itd.
Stoimy w miejscu, gdzie manipulacja DNA przypomina zabawę klockami Lego lub edycję tekstu w programie. Powinniśmy sobie (jako ludzkości) gratulować, ale nie w tyle głowy nie może przestać palić się światło ostrzegawcze.
Źródło: Live Science